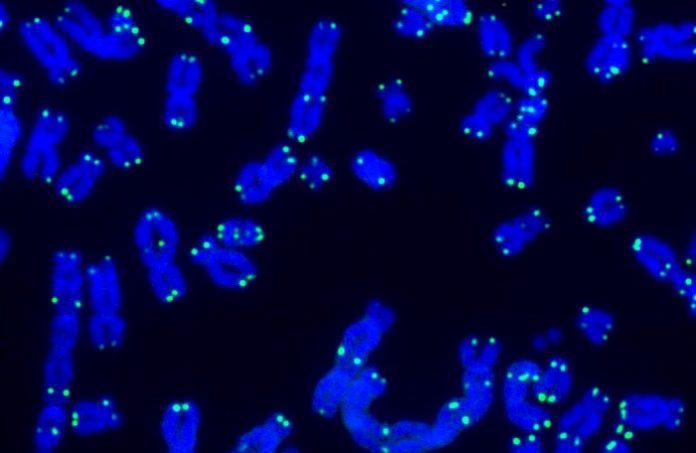
Теломеры и клеточное старение — методы и оборудование

Теломеры и клеточное старение: оборудование для исследований
Теломеры и клеточное старение: методы и оборудование для измерения длины теломер
Теломеры — защитные концевые участки хромосом, состоящие из повторов TTAGGG. При каждом делении клетки теломеры укорачиваются на 50–200 пар нуклеотидов. Когда длина достигает критического минимума, клетка входит в состояние репликативного старения (senescence), секретируя провоспалительные факторы (SASP).
Длина теломер — один из наиболее популярных маркеров биологического возраста в Anti-Age медицине. Однако клиническая ценность зависит от выбора метода измерения — разные подходы дают существенно разные результаты.
Методы измерения длины теломер
Сравнительная характеристика основных методов:
| Метод | Принцип | Точность | Пропускная способность | Оборудование |
|---|---|---|---|---|
| TRF (Southern blot) | Рестрикция + гибридизация | Высокая (kb) | Низкая | Электрофорез, блоттинг |
| qPCR (T/S ratio) | Сравнение с однокопийным геном | Средняя | Высокая | qPCR-термоциклер |
| Flow-FISH | PNA-зонды + проточная цитометрия | Высокая (на клетку) | Средняя | Проточный цитометр |
| HT Q-FISH | Флуоресцентная микроскопия | Максимальная (на хромосому) | Низкая | Автоматизированный микроскоп |
| DNAmTL | Метилирование как суррогат | Средняя | Высокая | EPIC микрочип / NGS |
Сенесцентные клетки и SASP-факторы
Помимо длины теломер, для полной оценки клеточного старения важно определять маркеры сенесцентных клеток:
- SA-β-galactosidase — классический маркер клеточного старения. Определяется цитохимически (pH 6.0) или флуориметрически (C₁₂FDG).
- GDF15 — циркулирующий SASP-фактор, один из лучших плазменных маркеров старения. Определяется ELISA или иммунохемилюминесцентно.
- IL-6, MCP-1, PAI-1 — провоспалительные цитокины SASP-комплекса. Мультиплексный анализ (MSD V-PLEX, Luminex).
- p16ʰⁿ⁴ᵃ экспрессия — маркер необратимого клеточного старения. Определяется RT-qPCR.
Оборудование для лаборатории
Комплект оборудования для комплексной оценки клеточного старения:
- qPCR-термоциклер — Bio-Rad CFX96/CFX384, Roche LightCycler 480. Для T/S ratio и RT-qPCR (p16).
- Проточный цитометр — BD FACSCanto II, Beckman CytoFLEX. Для Flow-FISH и SA-β-gal.
- Автоматизированный микроскоп — MetaSystems, Leica Microsystems. Для HT Q-FISH и цитохимического SA-β-gal.
- ELISA-ридер + мультиплексная платформа — для SASP-факторов (GDF15, IL-6, MCP-1).
- Система экстракции ДНК — для стандартизированной пробоподготовки.
KombiMED: оборудование для измерения теломер и маркеров старения
KombiMED GmbH поставляет полный комплект оборудования для измерения длины теломер и оценки клеточного старения — от qPCR-термоциклеров до проточных цитометров и автоматизированных микроскопов. Интеграция с эпигенетическими часами и маркерами оксидативного стресса создаёт комплексную панель оценки старения. Свяжитесь с нами для консультации.